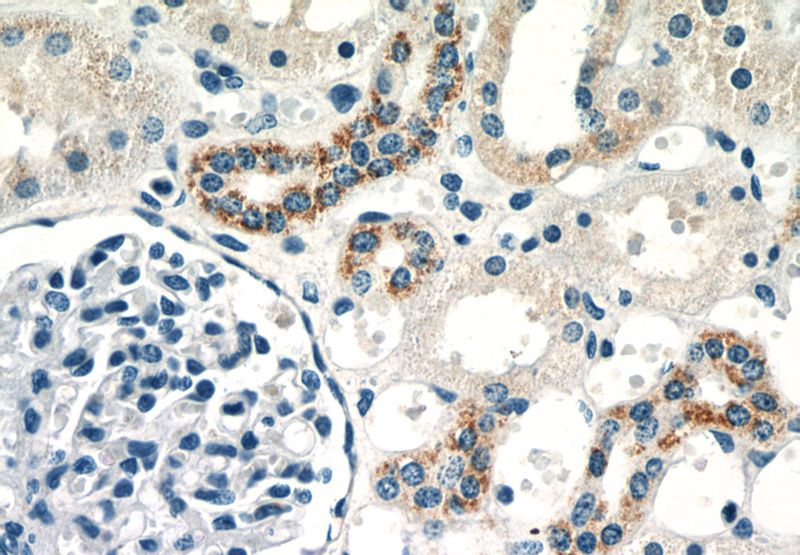
Immunohistochemistry of paraffin-embedded human kidney slide using Catalog No:112034(GLS Antibody) at dilution of 1:50

-
Product Name
KGA/GAM/GAC antibody
- Documents
-
Description
KGA/GAM/GAC Rabbit Polyclonal antibody. Positive WB detected in HEK-293 cells, HeLa cells, mouse brain tissue, mouse liver tissue, rat brain tissue. Positive IP detected in HEK-293 cells. Positive IHC detected in human kidney tissue, human brain tissue. Positive IF detected in HEK-293 cells, HeLa cells. Observed molecular weight by Western-blot: 58 kDa, 83 kDa
-
Tested applications
ELISA, IHC, IF, WB, IP
-
Species reactivity
Human, Mouse, Rat; other species not tested.
-
Alternative names
AAD20 antibody; DKFZp686O15119 antibody; FLJ10358 antibody; GAC antibody; GAM antibody; GLS antibody; GLS1 antibody; glutaminase antibody; K glutaminase antibody; KGA antibody; KIAA0838 antibody; L glutamine amidohydrolase antibody
-
Isotype
Rabbit IgG
-
Preparation
This antibody was obtained by immunization of KGA/GAM/GAC recombinant protein (Accession Number: NM_014905). Purification method: Antigen affinity purified.
-
Clonality
Polyclonal
-
Formulation
PBS with 0.02% sodium azide and 50% glycerol pH 7.3.
-
Storage instructions
Store at -20℃. DO NOT ALIQUOT
-
Applications
Recommended Dilution:
WB: 1:200-1:2000
IP: 1:500-1:5000
IHC: 1:20-1:200
IF: 1:10-1:100
-
Validations

Immunohistochemistry of paraffin-embedded human kidney slide using Catalog No:112034(GLS Antibody) at dilution of 1:50
Immunohistochemistry of paraffin-embedded human kidney slide using Catalog No:112034(GLS Antibody) at dilution of 1:50

HEK-293 cells were subjected to SDS PAGE followed by western blot with Catalog No:112034(GLS Antibody) at dilution of 1:600

IP Result of anti-GLS (IP:Catalog No:112034, 4ug; Detection:Catalog No:112034 1:1000) with HEK-293 cells lysate 1200ug.

Immunofluorescent analysis of HEK-293 cells using Catalog No:112034(GLS Antibody) at dilution of 1:25 and Rhodamine-Goat anti-Rabbit IgG
-
Background
GLS, also named as GLS1 and KIAA0838, belongs to the glutaminase family. It catalyzes the first reaction in the primary pathway for the renal catabolism of glutamine. Glutaminase-, glutamate-, and taurine-immunoreactive neurons develop neurofibrillary tangles in Alzheimer's disease.The glutaminase band in AA/C1 cells is more intense than in HT29 cells, in accordance with measurements of glutaminase activity, and had the same molecular mass of approx. 63 kDa(PMID:12408749). Ping Gao et al. (2009) determined that mitochondrial glutaminase expression (GLS, molecular mass of ~58 kDa) is increased ~10-fold in response to Myc. It also reveals a molecular weight of 83-84 kDa as a phosphate-dependent glutaminase(PMID:447624;7512428). GLS has 3 isoforms produced by alternative splicing and this antibody is specific to the 3 isoforms(KGA,GAM,GAC) of GLS.
-
References
- Smith MR, Vayalil PK, Zhou F. Mitochondrial thiol modification by a targeted electrophile inhibits metabolism in breast adenocarcinoma cells by inhibiting enzyme activity and protein levels. Redox biology. 8:136-148. 2016.
Related Products / Services
Please note: All products are "FOR RESEARCH USE ONLY AND ARE NOT INTENDED FOR DIAGNOSTIC OR THERAPEUTIC USE"
